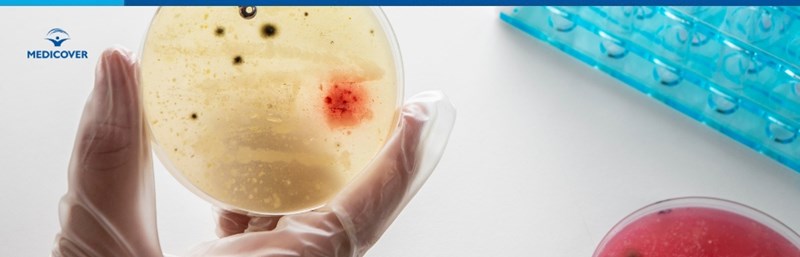

Incidenta la nivelul populatiei generale de ambele sexe este cuprinsa intre 1-1.3%, iar in cazul persoanelor diagnosticate cu uretrite non-gonococice aceasta creste pana la 10-35%.
Evolutia indelungata asimptomatica reprezinta principalul motiv de subdiagnosticare al infectiilor cauzate de Mycoplasma genitalium, de regula, investigatiile pentru depistarea patogenului fiind realizate dupa cronicizarea patologiei si instalarea disconfortului algic pelvin asociat cervicitei cronice si bolii inflamatorii pelvine. In prezent se estimeaza faptul ca aproximativ 5-10% din numarul total al infectiilor cu M.genitalium raman nediagnosticate datorita evolutiei asimptomatice al acestui tip de boala cu transmitere sexuala - BTS.
Cuprins
- Infectiile cu Mycoplasma Genitalium
- Mycoplasma Genitalium – cauze si factori de risc
- Simptome frecvente in infectia cu Mycoplasma Genitalium
- Diagnosticarea infectiilor cu Mycoplasma Genitalium
- Tratamentul infectiilor cauzate de M.genitalium
- Complicatii ale infectiilor cu M.genitalium
- Cum pot fi prevenite bolile cauzate de Mycoplasma genitalium?
Sumar: - Mycoplasma genitalium este asociat cu infectii ale organelor genitale si ale tractului urinar la ambele sexe. |
Infectiile cu Mycoplasma Genitalium
M.genitalium poate cauza uretrita non-gonococica si infertilitate atat la persoane de sex feminin, cat si masculin, prostatita la barbati, cervicita si boala inflamatorie pelvina la femei.
Mycoplasma Genitalium – cauze si factori de risc
Microorganismul face parte din categoria bolilor cu transmitere sexuala (BTS) si este transmis, in principal, prin contact vaginal si/sau anal fara utilizarea prezervativului, astfel incat principalii factori de risc asociati infectiilor cauzate de M.genitalium sunt reprezentati de contactul intim neprotejat cu o persoana infectata, debutul precoce al vietii sexuale si promiscuitatea sexuala.
O alta modalitate de transmitere a infectiei cauzate de M.genitalium este cea verticala de la mama la fat, care are loc in timpul nasterii, acest mecanism explicand prezenta microorganismului la nivelul cailor respiratorii ale nou-nascutului.
Simptome frecvente in infectia cu Mycoplasma Genitalium
Principalele manifestari care intra in alcatuirea tabloului clinic al infectiilor cauzate de M.genitalium includ:
- Disconfort algic pelvin spontan
- Dispareunie (durere la contactul intim)
- Leucoree (scurgeri vaginale modificate)
- Sangerari vaginale spontane sau dupa activitatea sexuala in afara menstruatiei
- Disurie (dificultate/disconfort la urinare)
- Polakiurie (urinare frecventa)
- Infertilitate secundara atat la barbati, cat si la femei.
Suplimentar, in cazul barbatilor, infectia poate cauza:
- Durere la nivelul pelvisului si in timpul ejacularii
- Prurit (mancarimi) local
- Eritem si/sau edem al glandului
- Aparitia de secretii uretrale modificate.
Aceste manifestari clinice tind sa fie recurente, in ciuda tratamentelor antibiotice urmate de catre pacient, datorita capacitatii microorganismului de a dezvolta rapid mecanisme de adaptare care ii asigura rezistenta la diferite clase de antibioterapice.
Infectiile la nivelul rectului evolueaza de regula asimptomatic sau in cazul in care apar, manifestarile clinice sunt nespecifice.
Diagnosticarea infectiilor cu Mycoplasma Genitalium
Diagnosticul infectiilor cauzate de M.genitalium este stabilit de catre medicul ginecolog, urolog sau dermato-venerolog dupa prelevarea de secretii uretrale la barbat si vaginale/cervicale la persoanele de sex feminin si testarea produselor biologice pentru depistarea patogenului cu ajutorul tehnicilor de biologie moleculara PCR.
Microorganismul poate fi detectat și în urina persoanei infectate (atat la femei, cat si la barbati) si presupune recoltarea a 10 ml de urina din primul jet la 2 ore distanta de la ultima mictiune, fara toaleta locala prealabila.

Tratamentul infectiilor cauzate de M.genitalium
Tratamentul patologiilor urogenitale cauzate de acest microorganism este etiologic si implica administrarea de antibiotice, in conformitate cu recomandarile medicului curant. Este util de mentionat faptul ca este deosebit de importanta respectarea cu strictete a schemei de tratament prescrise de catre medicul curant, pentru a nu favoriza aparitia rezistentei microorganismului la anumite clase de antibioterapice.
Tratamentul este efectuat, de regula, de ambii parteneri ai cuplului, medicul specialist indrumand pacientii sa practice abstinenta sexuala pe durata administrarii antibioticului sau sa utilizeze prezervativ in timpul actului sexual pana la finalizarea terapiei si negativarea testelor de laborator.
Complicatii ale infectiilor cu M.genitalium
Principalele complicatii care pot surveni pe fondul cronicizarii infectiilor cauzate de Mycoplasma genitalium se refera la:
- Sindrom inflamator cronic pelvin
- Endometrita
- Salpingita recurenta
- Sarcina ectopica
- Nastere prematura in cazul infectiilor care survin pe durata sarcinii
- Proctita (inflamatia mucoasei rectale), uretrita si infertilitate atat la femei, cat si la barbati.
Cum pot fi prevenite bolile cauzate de Mycoplasma genitalium?
- Preventia eficienta impotriva infectiilor cauzate de catre M.genitalium presupune abstinenta sexuala, monogamia, practicarea de relatii intime protejate si testarea periodica, inclusiv a partenerului/partenerilor pentru depistarea bolilor cu transmitere sexuala.
- Igienizarea riguroasa a jucariilor sexuale si evitarea utilizarii la comun a acestora cu alte persoane constituie o alta metoda de preventie atat a infectiilor cauzate de Mycoplasma sau Chlamydia trachomatis, cat si al altor boli cu transmitere sexuala.
Efectuarea regulata a vizitelor la ginecolog, in conformitate cu istoricul de boala personal si recomandarile medicului, permit depistarea precoce atat a infectiilor cu transmitere sexuala, cat si al altor patologii ale tractului genital feminin, indiferent de etiologia acestora si instituirea de tratament specific care previne aparitia complicatiilor pe termen scurt si lung.
Referire:
- About Mycoplasma genitalium, CDC
- Mycoplasma genitalium – a better known microorganism and its implications in an old gynecological patholog
- Mycoplasma Genitalium (Mgen), Cleveland Clinic
- What Is Mycoplasma Genitalium?
Intrebari Frecvente (FAQ)
1. Cine poate fi afectat de infectiile cu Mycoplasma genitalium?
Persoanele de ambele sexe pot fi afectate de infectiile cu Mycoplasma genitalium, iar incidenta este mai crescuta in randul celor diagnosticati cu uretrite non-gonococice.
2. Cum se transmit infectiile cauzate de Mycoplasma genitalium?
Aceste infectii sunt transmise in principal prin contact sexual neprotejat, dar si vertical de la mama la fat in timpul nasterii.
3. Ce simptome pot aparea in cazul infectiilor cu Mycoplasma genitalium?
Simptomele includ disconfort pelvin, dureri la contactul intim, scurgeri vaginale modificate si dificultati la urinare, iar la barbati pot aparea si dureri in timpul ejacularii.
4. Cum se realizeaza diagnosticarea infectiilor cu Mycoplasma genitalium?
Diagnosticarea se efectueaza de catre medici specialisti prin prelevarea de secretii sau urina pentru testare cu metodele de biologie moleculara PCR.